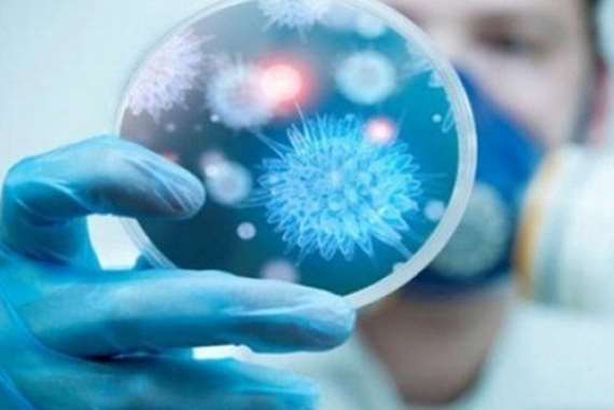
أرشيفية

في الوقت الذي لم يعلن فيه حتى الآن التوصل إلى مصل لمقاومة فيروس كورونا الجديد، الذي كانت بداية انتشاره في مدينة "ووهان" الصينية في ديسمبر الماضي، سارعت منظمة الصحة العالمية إلى دحض الخرافات المتعلقة بأساليب مقاومة المرض المميت.
وحذر البروفيسور بول هانتر، من كلية نورويتش الطبية بجامعة "إيست أنجليا" من أن "أي معلومات مضللة وغير صحيحة بشأن الفيروس، قد يؤدي إلى اتباع نصيحة غير سليمة، ما يؤدي إلى تفاقم "مخاطر أكبر" ويزيد الأمر سوءا بعد الإصابة بالمرض".
وتتضمن قائمة الخرافات التي عرضتها منظمة الصحة العالمية، ونشرتها صحيفة "ديلي ميل" البريطانية، 13 خرافة على النحو التالي:
1- مجففات اليد لن تقتل الفيروس
مجففات اليد وحدها لا يمكن أن تقتل بكتيريا فيروس "كورونا".
وذكرت صحيفة "تشاينا ديلي"، أن الشائعات الرائجة، تدعي أن استخدام الهواء الساخن من المجفف لمدة 30 ثانية سيؤدي إلى التخلص من أي أثر للفيروس على يديك.
لكن الصحيفة أكدت أن الأهم من ذلك هو أنه على الناس التركيز على نظافة أيديهم طوال الوقت.
وقالت منظمة الصحة العالمية: "لحماية نفسك من فيروس "كورونا" المستجد، يجب عليك تنظيف يديك بشكل متكرر بفرك لليدين على الكحول أو غسلها بالماء والصابون، وبمجرد تنظيف يديك، يجب عليك تجفيفهما جيدًا باستخدام المناشف الورقية أو مجفف الهواء الدافئ".
2- مصابيح الأشعة فوق البنفسجية لا تعقم الجلد
المصابيح التي تضخ الأشعة فوق البنفسجية في الجلد لن تعقمها. وحذرت منظمة الصحة العالمية من أن المصابيح يمكن أن تسبب تهيج الجلد.
3- تناول الثوم لا يقي من الفيروس
قالت منظمة الصحة العالمية إن الثوم غذاء صحي قد يحتوي على بعض الخصائص المضادة للميكروبات، ومع ذلك، لا يوجد أي دليل على أن تناول الثوم يحمي الأشخاص من فيروس "كورونا" المستجد.
وحظر موقع "فيسبوك" للتواصل الاجتماعي، نشر أي معلومات حول أن "وعاء من ماء الثوم المغلي يمكن أن يعالج علاج الفيروس التاجي الجديد لعام 2019".
4- زيت السمسم لا يمنع فيروس "كورونا" من دخول الجسم
زيت السمسم عنصر أساسي في الطبخ الآسيوي، ولكن فركه على الجلد لن يمنع فيروس كورونا من الدخول إلى الجسم.
وقالت منظمة الصحة العالمية: "لا، زيت السمسم لا يقتل فيروس "كورونا" المستجد".
5- رش الكحول أو الكلور على الجسم لن يقضي على الفيروس
بمجرد دخول فيروس "كورونا" إلى الجسم، إن رش أي مواد مثل الكحول والكلور على الجلد غير مفيدة.
ولا توجد معلومات مؤكدة حول ما إذا كان يمكن لأي شخص الإصابة بفيروس "كورونا" المستجد، عن طريق لمس سطح أو كائن يحمل الفيروس، ثم لمس فمه أو أنفه أو عينيه بعدها.
لكن بشكل عام، هناك بعض المطهرات الكيميائية القوية التي يمكن أن تقتل الفيروس التاجي، مثل مواد التبييض والمطهرات القائمة على الكلور، لكن لا ينبغي أن تستخدم على الجلد، لأن هذا يمكن أن يكون خطيرا، كما أنه لا ينصح باستنشاقه، بحسب منظمة الصحة العالمية.
وتنصح المنظمة: "كن على دراية بأن الكحول والكلور يمكن أن يكون مفيد لتطهير الأسطح، لكن يجب استخدامها في إطار التوصيات المناسبة".
6- الماسحات الحرارية غير فعالة دائما في الكشف عن الأشخاص المصابين
تستخدم الماسحات الضوئية الحرارية في جميع أنحاء العالم في المطارات ومحطات السكك الحديدية، وبإمكانها الكشف عن الأشخاص المصابين بالحمى، وإصابتهم بدرجة حرارة أعلى من المعتاد.
وقالت منظمة الصحة العالمية إن الماسحات قادرة على الكشف عن الأشخاص الذين لم يصابوا بالحمى بعد، وقد يستغرق الأمر من يومين إلى 10 أيام قبل أن يصاب الأشخاص بالحمى، وفي بعض الحالات، قد يستغرق الأمر 14 يوما.
7- الرسائل والطرود القادمة من الصين خالية من "كورونا"
قالت منظمة الصحة العالمية إنه من الآمن تلقي الطرود من الصين، إذ يظهر التحليل أن الفيروسات التاجية لا تصمد لفترة طويلة على الأشياء والجماد، خاصة في حالات الطيران بين البلدان.
8- الحيوانات الأليفة لا يمكن أن تصاب بـ"كورونا"
من المفهوم أن "كورونا" انتقل إلى إنسان من حيوان في سوق للمواد الغذائية في ووهان بالصين، ومع ذلك، فإنه في الوقت الحاضر، لا يوجد دليل على أن الحيوانات الأليفة يمكن أن تكون مصابة بالفيروس التاجي.
وذكرت وسائل إعلام محلية صينية، أن قطط وكلاب تم رميها من نوافذ المنازل لقتلهم، خوفًا من عدوى "كورونا"، بحسب صحيفة "ذا صن" البريطانية، لكن تقول منظمة الصحة العالمية إن هذه التدابير غير ضرورية.
وأضافت: "من الجيد دائما غسل يديك بالماء والصابون بعد ملامسة الحيوانات الأليفة، هذا يحميك من البكتيريا الشائعة المختلفة، مثل "إيكولاي" و"سالمونيلا"، التي من الممكن أن تنتقل بين الحيوانات الأليفة والبشر".
9- اللقاحات ضد الالتهاب الرئوي لن تحمي من "كورونا"
لا تزال اللقاحات المضادة لفيروس "كورونا" المستجد في طور الإعداد، ومن غير المرجح أن تنتهي في الوقت المناسب لكبح انتشار المرض الحالي.
ويتسابق الباحثون في جميع أنحاء العالم لتطوير دواء بدعم من منظمة الصحة العالمية.
وتقول المعاهد الوطنية للصحة في الولايات المتحدة، وجامعة بايلور في واكو، تكساس، إنها تعمل على تطوير لقاح يستند إلى ما يعرفانه عن فيروس كورونا بشكل عام، وباستخدام معلومات من تفشي فيروس "سارس"، ولكن هذا قد يستغرق عام أو أكثر لظهوره وتوفيره للجمهور للعام.
ولم تنجح المضادات المقاومة للالتهاب الرئوي، الذي يمكن أن يسببه فيروس "كورونا" في القضاء عليه.
10- رذاذ الأنف المالح لن يحميك
قالت منظمة الصحة العالمية، إنه لا يوجد دليل على أن شطف الأنف بانتظام بمحلول ملحي، يحمي الناس من الإصابة بفيروس "كورونا" المستجد.
11- غسول الفم لا يوفر أي حماية
غسول الفم لا يمكن أن يحميك من الإصابة بفيروس كورونا الجديد، وقد تتخلص بعص أنوع غسول الفم من بعض الميكروبات لبضع دقائق في اللعاب في فمك.
12- صغار السن والشباب غير معفيين للإصابة بالفيروس
يتعرض الشباب وصغار السن أيضا لمخاطر الإصابة بفيروس "كورونا" المستجد، على الرغم من أنه من الشائع أن كبار السن معرضون للإصابة به بشكل أكبر.
وقالت وسائل الإعلام الحكومية في مدينة ووهان الصينية، إن أصغر طفل يتم تشخيصه بالفيروس، هو طفل صيني مولود في الثاني من فبراير الجاري، وثبتت إصابته بعد 30 ساعة فقط من الولادة.
ويبدو أن كبار السن والأشخاص الذين يعانون من حالات طبية سابقة، مثل الربو والسكري وأمراض القلب، أكثر عرضة للإصابة بالفيروس.
وتنصح منظمة الصحة العالمية الأشخاص من كافة الأعمار، باتخاذ خطوات لحماية أنفسهم من الفيروس، مثل اتباع النظافة الشخصية الجيدة، والنظافة الشخصية الجيدة في الجهاز التنفسي.
13- المضادات الحيوية لن تعالج "كورونا"
توضح منظمة الصحة العالمية أن "كورونا" فيروس، وبالتالي، يجب عدم استخدام المضادات الحيوية كوسيلة للوقاية أو العلاج منه، إذ أن المضادات الحيوية تعمل فقط ضد الالتهابات البكتيرية.
وقالت منظمة الصحة العالمية "إذا كنت في المستشفى بسبب "كورونا"، فقد تتلقى المضادات الحيوية لأن العدوى البكتيرية المشتركة ممكنة".
وحتى الآن، لا يوجد دواء محدد موصى به لمنع أو علاج فيروس "كورونا" الجديد.